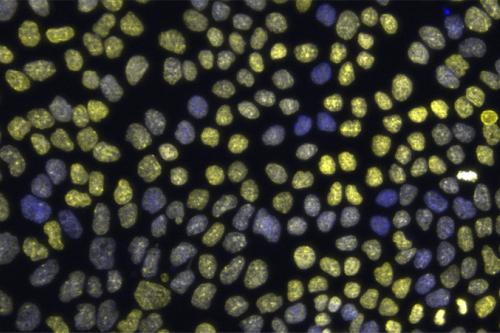
An image showing epithelial chromatin variation, with DNA (blue) and histone marker H3K27me3 (yellow) that represses gene activity

Neil Lin, Ph.D.
- Assistant Professor, Mechanical and Aerospace Engineering

Neil Lin, Ph.D., develops technologies that enable the creation of advanced, 3D-printed tissues that mimic human organs and their responses to treatments. This research could transform drug screening processes and one day lead to the development of artificial organs for human transplantation.
Lin specializes in creating 3D-printed tissues and microphysiological systems that mimic the genomic structure, mechanical properties and functionality of human organs. His work focuses on understanding how physical cues influence tissue properties, with a particular emphasis on the mechanical interactions between epithelial cells and their impact on gene expression and cell differentiation.
Lin develops mechano-engineering strategies, microscopy methods and characterization tools to investigate complex interactions such as cell-cell adhesion, cell-substrate traction and cell-flow dynamics. This work could enable greater understanding of tissue properties and mechanobiology and lead to innovative therapies for cancer and genetic diseases.
He also employs artificial intelligence to enhance his research capabilities — he has developed machine learning models to identify mesenchymal stromal cell, or MSC, characteristics in live cell cultures. Found primarily in the bone marrow, MSCs are a type of tissue stem cell with great potential for regenerative medicine, tissue repair, immunotherapy and targeted drug delivery. This AI-based approach enables non-invasive, real-time analysis of cell cultures, which is crucial for high-throughput drug screening and quality control in cell therapies.
By bridging the gap between engineering, biology and artificial intelligence, Lin's research could pave the way for advanced cell cultures that facilitate drug screening, the development of novel therapies and organ transplantation.
Research Projects
- Developing 3D tissue models and systems that better mimic how patients respond to treatments
- Creating imaging tools to visualize cell phenotypes within live, 3D in vitroA process, procedure or study performed in a test tube or lab dish rather than in a living organism.in vitroA process, procedure or study performed in a test tube or lab dish rather than in a living organism. tumor tissue
- Exploring novel cell culture methods using flow culture to better mimic in vivoA process, procedure or study performed on or in a living organism.in vivoA process, procedure or study performed on or in a living organism. conditions
- Leveraging AI models to analyze live cell images and extract molecular information
- Utilizing 3D spheroids and organoids to model tumor and tissue microenvironments
-
Post-doctoral Fellowship
- Tissue Engineering, 3D Bioprinting, Harvard University, 2019
Degree
- Ph.D., Physics, Cornell University, 2016